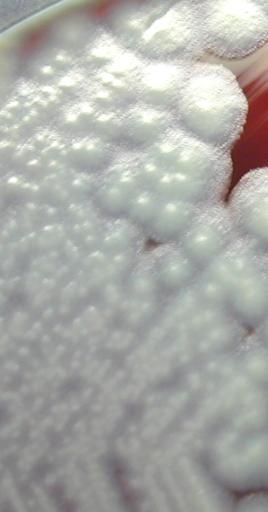

MAKE A MEME
View Large Image
| View Original: | Bacillus_cereus_011.png (270x516) | |||
| Download: | Original | Medium | Small | Thumb |
| Courtesy of: | commons.wikimedia.org | More Like This | ||
| Keywords: Bacillus cereus 011.png en Bacillus cereus 011 2014-04-07 07 23 03 https //upload wikimedia org/wikipedia/commons/0/02/Bacillus_cereus_01 png This media comes from the Centers for Disease Control and Prevention's Public Health Image Library PHIL with identification number 1924 Note Not all PHIL images are public domain; be sure to check copyright status and credit authors and content providers PD-USGov Uploaded with UploadWizard Bacillus cereus | ||||